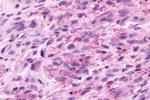
Prokineticin Receptor 2 Antibody in Immunohistochemistry (Paraffin) (IHC (P))

Search
Invitrogen
Prokineticin Receptor 2 Polyclonal Antibody
{{$productOrderCtrl.translations['antibody.pdp.commerceCard.promotion.promotions']}}
{{$productOrderCtrl.translations['antibody.pdp.commerceCard.promotion.viewpromo']}}
{{$productOrderCtrl.translations['antibody.pdp.commerceCard.promotion.promocode']}}: {{promo.promoCode}} {{promo.promoTitle}} {{promo.promoDescription}}. {{$productOrderCtrl.translations['antibody.pdp.commerceCard.promotion.learnmore']}}
产品信息
OPA1-15292
宿主/亚型
分类
类型
抗原
偶联物
形式
浓度
规格
保存条件
运输条件
RRID
产品详细信息
OPA1-15292 has been successfully used in immunohistochemistry procedures. By immunohistochemistry, OPA1-15292 detects the prokineticin receptor 2 (GPR73B) in formalin fixed, paraffin embedded human tissues.
靶标信息
Prokineticins are secreted proteins that can promote angiogenesis and induce strong gastrointestinal smooth muscle contraction. GPR73B is an integral membrane protein and G protein-coupled receptor for prokineticins. The encoded protein is similar in sequence to GPR73, another G protein-coupled receptor for prokineticins. GPCR73B expression has been reported in brain, ovary, salivary gland, small intestine (ileocecum), testis, and thyroid. No human ESTs have been identified.
仅用于科研。不用于诊断过程。未经明确授权不得转售。